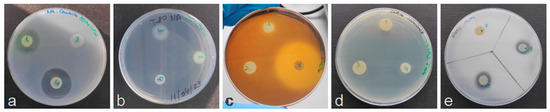

Abstract
In agroecosystems, bacterial antagonism is an alternative to agrochemicals, which are a threat to the environment and global health. From this perspective, a collection of environmental bacterial isolates was tested for their potential as antagonists against the phytopathogenic bacterium Xanthomonas vesicatoria, which is one of the etiological agents of bacterial spot in tomato and pepper. The isolates with the greatest in vitro antagonistic activity were selected for ex vivo assays using tomato plant leaves and further characterized for their capacity to produce hydrolytic enzymes. The results revealed promising prospects for an antagonism-based X. vesicatoria biocontrol against bacterial spot disease, thus favouring more sustainable agricultural production.
1. Introduction
Xanthomonas vesicatoria is one of the phytopathogenic species responsible for bacterial spot of tomato and pepper, a disease with significant economic impact on agroecosystems worldwide [1,2,3,4]. It is disseminated mainly through contaminated seeds and transplants and has been consistently detected on both greenhouse and field production systems [1,2]. Its survival is favoured by warm and humid conditions. The infection cycle comprises the epiphytic and endophytic stages [3]. In the epiphytic stage, bacteria are introduced into the aerial tissues of the host through natural openings and/or wounds; once inside, bacteria initiate the endophytic stage and colonise the host [3]. Symptoms begin as water-soaked lesions that later develop into chlorotic halos and progress into necrotic spots on the aerial parts [2]. The pathogen can persist during intercropping periods on volunteer tomato and pepper plants, on other species and weeds different from the hosts, and in plant debris in the soil [1,2]. X. vesicatoria synthesizes an extracellular polysaccharide named xanthan that enables the cells to form biofilms, which promote the bacterial establishment over the entry points within the first steps of the plant infection [4].
Management of the disease has traditionally been a major problem, since it is usually limited by the lack of resistant hosts, and the threat posed to the environment and global health by the continued use of agrochemical agents [1,3]. In the last years, biological control methods are being considered as a feasible alternative to conventional control measures in order to counteract the damage caused by pathogens in agroecosystems while allowing for their sustainability. One of these renewed methods is the use of microorganisms with effective antagonistic or inhibitory activity against one or more pathogens [5].
In this study, an attempt was made to overcome limitations in existing biocontrol options against the bacterial spot disease in tomato and pepper and to reduce the need for new antagonistic isolates by evaluating the potential of a collection of environmental bacteria against the phytopathogen X. vesicatoria. The best resulting isolates for biocontrol were also tested for hydrolytic enzyme production and nitrogen fixation in order to explore their potential for biotechnological use as well.
2. Materials and Methods
2.1. Bacterial Isolation
A collection of environmental bacteria was isolated from disease-free areas, and were routinely grown on the general culture media NB (Nutrient Broth) [5 g/L peptone, 1 g/L meat extract, 2 g/L yeast extract, 5 g/L NaCl] or NBA (Nutrient Broth Agar) [NB plus 15 g/L agar] at 28 °C for 24 or 48 h. Isolates were kept in 25% (v/v) glycerol at −20 °C until characterization. Reference X. vesicatoria strains CFBP 1941 and CECT 792 were used for the antagonistic assays.
2.2. Antagonistic Activity In Vitro
Ten bacterial isolates were tested for their in vitro antagonistic activity against the reference strains, according to [5]. Assays were carried out by plating streaks of suspensions of each of the bacterial isolates at 108 CFU/mL, and incubated at 28 °C for 48 h. Then, perpendicular streaks of suspensions of the X. vesicatoria reference strains at 107 CFU/mL were added and incubated under the same conditions. Ability to inhibit the growth of the pathogen by each of the isolates was determined by measuring the distance between streaks. Chloroform was additionally applied to look for activity due to the presence of diffusible compounds. All assays were performed in duplicate and repeated in an independent experiment.
2.3. Antagonistic Activity Ex Vivo
The five bacterial isolates with the greatest in vitro antagonistic activity were selected for ex vivo assays to determine antagonism in plant material against X. vesicatoria reference strains, using leaves from tomato plants of the variety Moneymaker, susceptible to the bacterial spot disease [6]. For inoculations, five wounds were made on each side from the central vein of the leaves with a sterile needle in duplicate. Then, 10 µL drops of suspensions of each of the bacterial isolates at 108 CFU/mL were deposited on the wounds. After one hour, 10 µL drops of suspensions of the X. vesicatoria reference strains at 107 CFU/mL were added. Negative and positive controls were considered. The leaves were incubated at 28 °C in optimal conditions for disease development. Monitoring for symptoms was carried out on days 3, 5, 7 and 10 after inoculation. All assays were performed with three technical and two biological replicates.
2.4. Production of Hydrolytic Enzymes and Fixation of Nitrogen
The bacterial isolates with the greatest ex vivo antagonistic activity were further characterized by their capacity to produce hydrolytic enzymes, such as proteases, lipases, amylases and DNases, and for their nitrogen fixation capacity, according to [5,7].
Regarding detection of proteolytic activity, isolates were grown on Skim Milk agar [50 g/L skim milk powder, 15 g/L agar]; for lipolytic activity, they were grown on Tween 80 medium [10 g/L peptone, 0.1 g/L CaCl2.2H2O, 10 mL/L Tween 80, 20 g/L agar]; for amylolytic activity, they were grown on Starch agar [10 g/L potato starch, 0.5 g/L KNO3, 1 g/L K2HPO4, 0.2 g/L MgSO4.7H2O, 0.1 g/L CaCl2, FeCl3 traces, 15 g/L agar], and after growth, addition of Lugol for one minute; for DNase activity, they were grown on DNase agar [20g/L tryptose, 2 g/L deoxyribonucleic acid, 5 g/L NaCl, 12 g/L agar] and then flooded with 1N HCl.
For the detection of nitrogen fixation capacity, isolates were grown on Norris medium [10 g/L glucose, 1 g/L K2PO4, 0.2 g/L MgSO4, 1 g/L CaCO3, 0.2 g/L NaCl, 0.005 g/L Na2MoO4, 0.1 g/L FeSO4, 15 g/L agar].
Plates were incubated at 28 °C, and bacterial activities were recorded after 48 h (proteolytic and lipolytic activities), 5 days (amylolytic and DNase activities) and 7 days (nitrogen fixation test). All assays were performed in duplicate and repeated in an independent experiment.
3. Results
3.1. Antagonistic Activity In Vitro
About 50% of the environmental bacterial isolates showed antagonistic activity against X. vesicatoria strains (Figure 1). Moreover, several of them were able to maintain their inhibitory activity after inactivation with chloroform, suggesting that their antagonism might be due to the presence of diffusible compounds.

Figure 1.
In vitro assays. Active (a) and inactive (b) bacterial isolates (vertical streaks) against the same strains of X. vesicatoria (perpendicular streaks). In (a), two of the X. vesicatoria streaks were inhibited in their growth in the presence of the bacterial isolate. In (b), all of them grew next to the isolate.
3.2. Antagonistic Activity Ex Vivo
By inoculation in leaves, some antagonists produced a reduction in symptoms of the bacterial spot disease caused by X. vesicatoria in the susceptible tomato variety Moneymaker (Figure 2). Symptoms began to appear between five and seven days after inoculation and were followed up for 10 days.

Figure 2.
Ex vivo assays. Tomato leaves were inoculated with: (a) bacterial antagonist, (b) bacterial antagonist and a reference X. vesicatoria strain, (c) the reference X. vesicatoria strain (positive control), and (d) phosphate-buffered saline (negative control). Leaves display results at 10 days post-inoculation.
3.3. Production of Hydrolytic Enzymes and Fixation of Nitrogen
With respect to the assays performed to determine activities related to the synthesis of exoenzymes and fixation of nitrogen, all the antagonists tested presented some of these activities of biotechnological interest (Figure 3). Data are presented in Table 1.
Figure 3.
Exoenzyme production and nitrogen fixation assays. The environmental bacterial isolates with inhibitory activity against X. vesicatoria were additionally plated on different culture media to detect: (a) proteolytic, (b) lipolytic, (c) amylolytic, (d) DNase activities, and (e) nitrogen fixation. Plates display examples of positive results. The presence of either transparent or translucent halos surrounding the colonies was correlated with positive activity in (a–d), whereas the presence of opaque zones around the colonies and the ability to grow were correlated, respectively, with the activities in (b,e).

Table 1.
Biological activities of the tested bacterial isolates.
4. Discussion
After the sequential selection process, the bacterial isolates that showed the highest inhibition of X. vesicatoria growth in vitro also reduced the severity of bacterial spot symptoms ex vivo, in addition to producing different hydrolases and fixing molecular nitrogen. Advantages in the application of beneficial bacteria have already been reported, mainly regarding plant growth promotion and protection against diseases, thereby contributing to crop productivity [5,7,8]. Although this work constitutes the first steps in controlled conditions, the prospects for improving biological control against bacterial spots caused by X. vesicatoria in tomato and pepper in field experiments are promising. Similarly, endophytic bacteria significantly reduced the incidence of pomegranate bacterial blight caused by X. axonopodis pv. punicae [9], and Bacillus subtilis was considered as a potential antagonistic agent for bacterial pustule in soybean caused by X. campestris pv. glycines [10]. Antagonism-based biocontrol was also effective against other phytopathogens [5,7,11,12], promoting sustainable agriculture and ecosystem balance. Limitations such as stability in field application or possible inhibition mechanisms should be addressed. Progress in formulations and ways for manufacturing and commercialization is needed to fully develop the potential of these kinds of biopesticides in terms of improvement of efficiency and cost effectiveness [8,11,12]. Another challenge for use in integrated crop management systems in the field is regulatory approval and farmer adoption.
Author Contributions
Conceptualization, B.Á. and E.G.B.; Methodology, B.Á., I.S., T.C., A.P.-B. and E.G.B.; Formal Analysis, B.Á. and E.G.B.; Writing, B.Á. and E.G.B.; Project Administration, E.G.B.; Funding Acquisition, E.G.B. All authors have read and agreed to the published version of the manuscript.
Funding
This work was supported by project I+D+i PID2021-123600OR-C44, funded by MICIU/AEI/10.13039/501100011033 and by ERDF, EU.
Institutional Review Board Statement
Not applicable.
Informed Consent Statement
Not applicable.
Data Availability Statement
Data are contained within the article.
Acknowledgments
Authors thank the “Ministerio de Ciencia, Innovación y Universidades (MICIU)” and the European Regional Development Fund (ERDF).
Conflicts of Interest
The authors declare no conflicts of interest.
References
- Osdaghi, E.; Jones, J.B.; Sharma, A.; Goss, E.M.; Abrahamian, P.; Newberry, E.A.; Potnis, N.; Carvalho, R.; Choudhary, M.; Paret, M.L.; et al. A Centenary for Bacterial Spot of Tomato and Pepper. Mol. Plant Pathol. 2021, 22, 1500–1519. [Google Scholar] [CrossRef] [PubMed]
- EPPO. PM 7/110 (2) Xanthomonas spp. (Xanthomonas euvesicatoria pv. euvesicatoria, Xanthomonas hortorum pv. gardneri, Xanthomonas euvesicatoria pv. perforans, Xanthomonas vesicatoria) Causing Bacterial Spot of Tomato and Sweet Pepper. EPPO Bull. 2023, 53, 558–579. [Google Scholar] [CrossRef]
- An, S.Q.; Potnis, N.; Dow, M.; Vorhölter, F.J.; He, Y.Q.; Becker, A.; Teper, D.; Li, Y.; Wang, N.; Bleris, L.; et al. Mechanistic Insights Into Host Adaptation, Virulence and Epidemiology of the Phytopathogen Xanthomonas. FEMS Microbiol. Rev. 2020, 44, 1–32. [Google Scholar] [CrossRef] [PubMed]
- Felipe, V.; Romero, A.M.; Montecchia, M.S.; Vojnov, A.A.; Bianco, M.I.; Yaryura, P.M. Xanthomonas vesicatoria Virulence Factors Involved in Early Stages of Bacterial Spot Development in Tomato. Plant Pathol. 2018, 67, 1936–1943. [Google Scholar] [CrossRef]
- Esteban-Herrero, G.; Álvarez, B.; Santander, R.D.; Biosca, E.G. Screening for Novel Beneficial Environmental Bacteria for an Antagonism-Based Erwinia amylovora Biological Control. Microorganisms 2023, 11, 1795. [Google Scholar] [CrossRef] [PubMed]
- Licciardello, G.; Caruso, P.; Bella, P.; Boyer, C.; Smith, M.W.; Pruvost, O.; Robene, I.; Cubero, J.; Catara, V. Pathotyping Citrus Ornamental Relatives with Xanthomonas citri pv. citri and X. citri pv. aurantifolii Refines Our Understanding of Their Susceptibility to These Pathogens. Microorganisms 2022, 10, 986. [Google Scholar] [CrossRef] [PubMed]
- Meza-Manzaneque, B.; Pérez-Díaz, M.; Biosca, E.G.; Álvarez, B. Isolation and Characterization of Agricultural Soil Bacteria with Biotechnological and Biological Control Potential Applications. Biol. Life Sci. Forum 2024, 31, 28. [Google Scholar] [CrossRef]
- Villavicencio-Vásquez, M.; Espinoza-Lozano, F.; Espinoza-Lozano, L.; Coronel-León, J. Biological Control Agents: Mechanisms of Action, Selection, Formulation and Challenges in Agriculture. Front. Agron. 2025, 7, 1578915. [Google Scholar] [CrossRef]
- Singh, N.V.; Sharma, J.; Dongare, M.D.; Gharate, R.; Chinchure, S.; Nanjundappa, M.; Parashuram, S.; Patil, P.G.; Babu, K.D.; Mundewadikar, D.M.; et al. In Vitro and In Planta Antagonistic Effect of Endophytic Bacteria on Blight Causing Xanthomonas axonopodis pv. punicae: A Destructive Pathogen of Pomegranate. Microorganisms 2023, 11, 5. [Google Scholar] [CrossRef] [PubMed]
- Salerno, C.M.; Sagardoy, M.A. Antagonistic Activity by Bacillus subtilis Against Xanthomonas campestris pv. glycines Under Controlled Conditions. Span. J. Agric. Res. 2003, 1, 55–58. [Google Scholar] [CrossRef]
- Negi, R.; Sharma, B.; Kaur, S.; Kaur, T.; Khan, S.S.; Kumar, S.; Ramniwas, S.; Rustagi, S.; Singh, S.; Rai, A.K.; et al. Microbial Antagonists: Diversity, Formulation and Applications for Management of Pest-Pathogens. Egypt. J. Biol. Pest Control 2023, 33, 105. [Google Scholar] [CrossRef]
- Giovanardi, D.; Biondi, E.; Biondo, N.; Quiroga, N.; Modica, F.; Puopolo, G.; Pérez Fuentealba, S. Sustainable and Innovative Biological Control Strategies Against Pseudomonas syringae pv. tomato, Pseudomonas savastanoi pv. phaseolicola and Xanthomonas spp. Affecting Vegetable Crops: A Review. Front. Plant Sci. 2025, 16, 1536152. [Google Scholar] [CrossRef] [PubMed]
Disclaimer/Publisher’s Note: The statements, opinions and data contained in all publications are solely those of the individual author(s) and contributor(s) and not of MDPI and/or the editor(s). MDPI and/or the editor(s) disclaim responsibility for any injury to people or property resulting from any ideas, methods, instructions or products referred to in the content. |
© 2025 by the authors. Licensee MDPI, Basel, Switzerland. This article is an open access article distributed under the terms and conditions of the Creative Commons Attribution (CC BY) license (https://creativecommons.org/licenses/by/4.0/).



